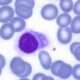
Leucemia de células pilosas

El riñón adquiere su forma característica similar a una semilla de haba o alubia por varias razones anatómicas y funcionales. Su eje está orientado medialmente, lo que significa que se encuentra más cerca del centro del cuerpo, cerca de la columna vertebral. Esta posición medial permite una distribución casi simétrica de los riñones a ambos lados de la columna vertebral.
La consistencia firme del riñón se debe a su estructura interna, que está compuesta principalmente por miles de nefronas, las unidades funcionales del riñón. Estas nefronas son responsables de filtrar y procesar los desechos y el exceso de agua del cuerpo. La firmeza del riñón es necesaria para mantener su integridad estructural y asegurar su adecuado funcionamiento.
La coloración rojo-violácea del riñón en el ser vivo, se debe a la abundante irrigación sanguínea que recibe. El riñón tiene una red de vasos sanguíneos que suministran oxígeno y nutrientes, y eliminan los productos de desecho. Esta irrigación sanguínea contribuye a su apariencia rojo-violácea.
El riñón tiene dos caras:
- la cara anterior
- la cara posterior.
La cara anterior es lisa, algo abollonada y convexa en el sentido vertical y transversal. Se ubica en dirección anterolateral. Por otro lado, la cara posterior es casi plana. Estas caras están diseñadas para adaptarse a las estructuras vecinas y facilitar su función.
Los bordes del riñón, el borde lateral es convexo y une las dos caras en una curva regular. El borde medial, por otro lado, es cóncavo y está interrumpido por el hilo del riñón, que es la región por donde ingresan y salen los vasos sanguíneos, los nervios y las vías excretoras. Los salientes superior e inferior del hilo corresponden a las extremidades superior e inferior del riñón.
El seno renal es una excavación romboidal en el riñón que está limitada por el parénquima renal. En el seno renal se encuentran las vías excretoras, los elementos vasculonerviosos de la raíz y el tejido adiposo. Es una región crucial para el flujo y drenaje adecuado de la orina.
Las extremidades del riñón también tienen características distintivas. La extremidad superior del riñón es ancha, redondeada y se inclina ligeramente hacia el sentido medial. Por otro lado, la extremidad inferior es más alargada y tiene una orientación más vertical.
Las dimensiones del riñón, en un adulto, cada riñón mide aproximadamente de 10 a 12 centímetros de alto, 5 a 8 centímetros de ancho y de 3 a 5 centímetros de espesor. El peso promedio de un riñón es de alrededor de 170 gramos. El volumen de ambos riñones tiende a ser similar.
Estas características anatómicas del riñón son importantes para su función de filtración y eliminación de desechos, así como para su ubicación y relación con otras estructuras cercanas en el cuerpo.

Síguenos en X: @el_homomedicus y @enarm_intensivo Síguenos en instagram: homomedicus y en Treads.net como: Homomedicus